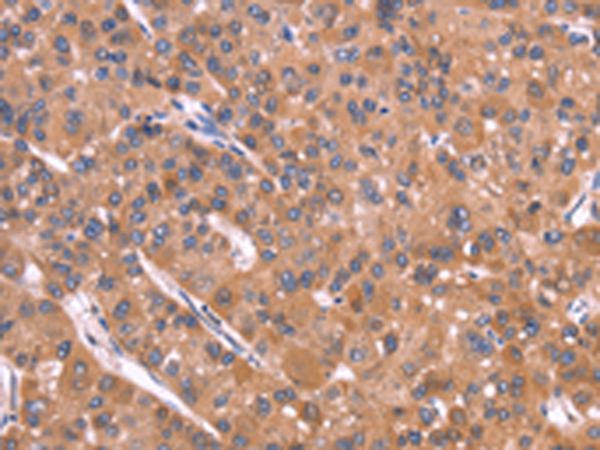
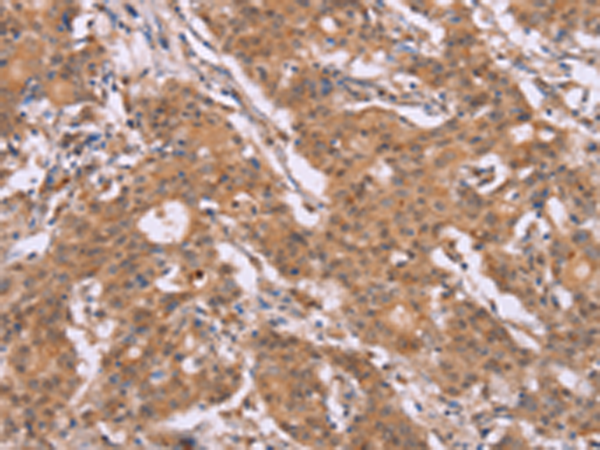

-
分类: 科研抗体货号: P08182别名: p38; CRKII应用: IHC反应种属: Human, Mouse, Rat
-
分类: 科研抗体货号: P08183别名: COT应用: WB,IHC反应种属: Human, Mouse, Rat
-
分类: 科研抗体货号: P08199别名:应用: IHC反应种属: Human
-
分类: 科研抗体货号: P08181别名: Aeg2; CRS3; SGP28; CRISP-3; dJ442L6.3应用: IHC反应种属: Human
-
分类: 科研抗体货号: P08198别名: CTX; CP27; CYP27应用: WB,IHC反应种属: Human, Mouse
-
分类: 科研抗体货号: P08209别名:应用: WB,IHC反应种属: Human
-
分类: 科研抗体货号: P08197别名: FHI; CPN1; CYP11B; P450C11应用: IHC反应种属: Human
-
分类: 科研抗体货号: P08208别名:应用: IHC反应种属: Human
-
分类: 科研抗体货号: P08196别名:应用: IHC反应种属: Human, Mouse
-
分类: 科研抗体货号: P08207别名: AREI; STF1; STFA应用: WB反应种属: Human, Mouse

鄂公网安备42018502007531号
鄂公网安备42018502007531号

